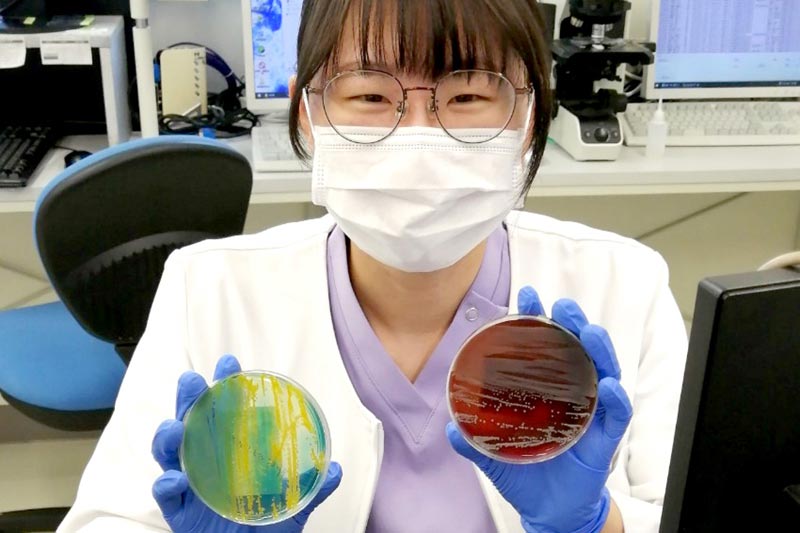

現場に強い
臨床検査部として
『私たちはハイブリッド臨床検査部』
をモットーに、24時間365日稼働する
救命救急センターの
臨床検査部として、
いつでも緊急検査に対応。
検査室だけでなく診療の現場で
プロフェッショナルとして
活動しています。
ワークライフバランスを大切にしながら
着実にキャリアアップできる
誰もが安心して働ける職場環境が
近森病院臨床検査部にはあります。
ハイブリッド
臨床検査部とは?
Hybrid
Clinical-laboratory
当院では、在籍している53人全ての臨床検査技師が自身の担当検査業務とは別の検査業務にも対応できるよう、研鑽を積んでいます。
ハイブリッド臨床検査部の強み Staff Voice
臨床の現場での活躍
- 救急外来(ER)、内視鏡センター、心カテ、アブレーションなど、活躍の場が幅広くあります。
- 現場に出向いて働いているので、沢山のことが学べます。
- 様々な症例を経験でき、知識や技術が身に付きます。
継続的なスキルアップ
- 有資格者が多く、個々のスキルが高いと感じています。
- 資格取得しやすい環境が整っています。
- 資格手当があるので、更なるやる気に繋がっています。
風通しの良い関係性
- 人員が多く、急な休みが発生してもカバーし合うことができます。
- 困っていたら助けてくれる優しいスタッフばかりです。
- お子さんがいらっしゃる方も多く、ママ世代も働きやすい環境です。
部署紹介 Department
データで見る
臨床検査部
questionnaire
各係の担当者数
(兼務あり)
Number of People
専門資格の取得者数 license
日本臨床細胞学会
細胞検査士
0人
日本臨床検査技師会
認定病理検査技師
0人
日本輸血・細胞治療学会
認定輸血検査技師
0人
日本臨床微生物学会
認定臨床微生物
検査技師
0人
日本超音波医学会
認定超音波検査士
(循環器)
0人
日本超音波医学会
認定超音波検査士
(血管)
0人
日本超音波医学会
認定超音波検査士
(消化器)
0人
日本消化器内視鏡学会
消化器内視鏡技師
0人
日本糖尿病療養指導士認定機構
日本糖尿病療養
指導士
0人
日本臨床衛生検査技師会
認定心電検査技師
0人
日本不整脈心電学会
認定心電図専門士
0人
高知県労働基準協会連合会
特定化学物質及び四アルキル鉛等作業主任者
0人
高知県労働基準協会連合会
有機溶剤作業
主任者
0人
日本心血管インターべーション治療学会
心血管インター
ベンション技師
0人
診療技師認定機構
(日本血管外科学会、日本脈管学会、日本静脈学会、日本動脈硬化学会 4学会構成)血管診療技師
0人
出身校 University
出身地 University
高知0人
愛媛0人
岡山0人
大阪0人
ほとんどのスタッフが高知県民です。
男女比 Gender Ratio
男
0%女
0%53名中、2名は男性技師です。
それぞれの強みを発揮しながら頑張っています。
年代
平均年齢は34.3歳!
20代、30代を中心とした活気ある職場です。
お子さんの数
乳幼児
0人小学生
0人中学生
0人合計
0人子育てに奮闘中の仲間も沢山います。
日本人全体の平均割合と同じ傾向でした。
ややA型が多い?
長子が一番多く、
一人っ子が一番少ない結果になりました。
通勤手段 Commute
0%
0%
0%
0%
お昼ご飯 Lunch
お弁当
0%コンビニ弁当
0%宅配弁当
0%職員食堂
0%お弁当派が多数という結果に。
頑張って作っていますね!?
趣味 Hobby
行動系
- 旅行、観光
- 食べ歩き
- カフェ巡り
- ドライブ
- 地域ボランティア
- 水泳
- ダイビング
- 弓道
- ソフトバレー
- 子どもの野球応援
文化系
- 読書・漫画
- 映画・ドラマ・アニメ鑑賞
- 猫動画鑑賞
- 音楽鑑賞
- ゲーム
- 手芸
- ラッピング
- 折り紙
その他
- Fx
- ワイン
- お菓子作り
- 美味しいものをお腹いっぱい食べる
- マスキングテープ収集
- シールのコレクション
- 腸活
- 娘と甥っ子を愛でる
- 心臓血管カテーテル
特におすすめしたいもの
漫画
- SPY×FAMILY
- ジョジョの奇妙な冒険
- ワールドトリガー
- ブラッククローバー
- キングダム
- 黄金のガッシュベル!!
読書
- 三体
- 流浪地球
- 老神介護
食べ物
- とり丑精肉店のコロッケ
- 無人販売「餃子の雪松」(にんにく注意!)
その他
- 地域の消防団員になってみては?
- 断捨離!不要な物を捨てるとスッキリします。
- 学会出張(笑)
推し活 Oshikatsu
推しが
いる
0%いない
0%- ジャニーズ
- なにわ男子
- Snow Man
- BTS
- BTS テテ♡
- TWICE サナ
- IVE
- K-POPなら何でも◎
- 菅田将暉
- 吉沢亮
- ポルノグラフィティ
- 声優全般
- 下野 紘
- ちいかわ
- 広く、浅く色々な方々が好きです。 など
100万円あったら…? One Million Yen
貯金
将来用に貯蓄
お祝い事の資金用に貯蓄
投資信託・NISA
株の購入
1ヶ月間で世界一周
外国旅行で行けるところまで!
韓国旅行したい
家族旅行
車の購入資金
大きいオーブンレンジに買い替え
家具・家電の新調
欲しいものを買う!
奨学金返済
住宅ローン返済
車のローン返済
犬・猫費用
宝くじ
推しに貢ぐ
友人と豪遊
高級料理を食べる
晩ご飯を作ってくれるお手伝いさんをお願いする
毎日ウーバーイーツする
旅行や購入資金、趣味などの使い道を考えている方でも半分を残し貯蓄・投資に回すなど、堅実な方が多いようです。
動物占い Animal Fortune Telling
動物占いとは?
「四柱推命」をベースにして、生年月日から分かるその人の性格や運勢を12の動物キャラに分類して分析したものです。1999年頃にブームになりました。
ゾウ
0%
チーター
0%
ライオン
0%
ペガサス
0%
ひつじ
0%
黒ヒョウ
0%
たぬき
0%
こじか
0%
狼
0%
猿
0%
コアラ
0%
虎
0%